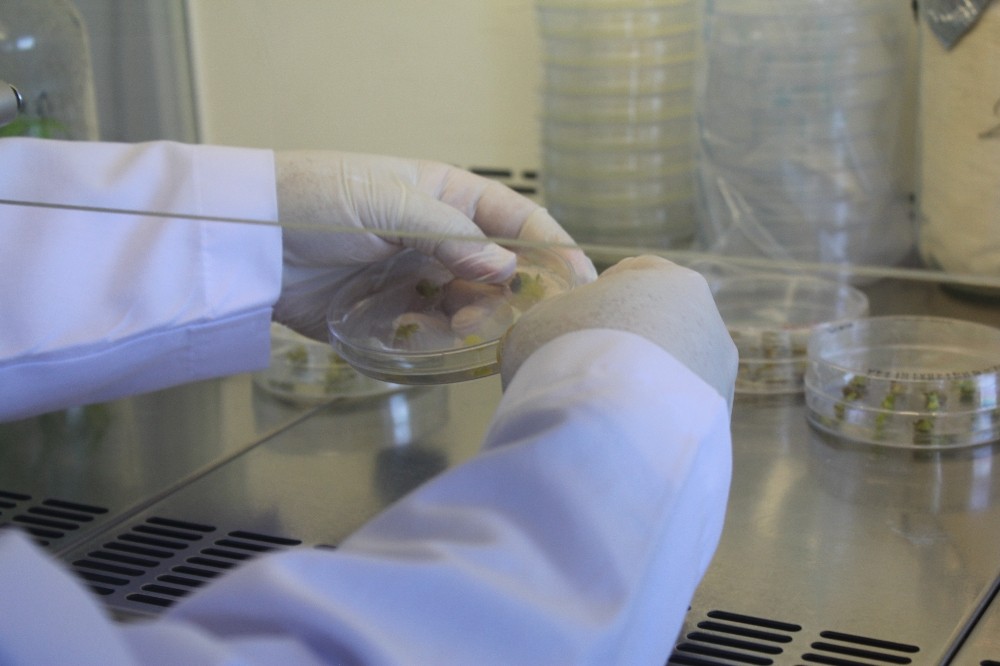
omulu ogrencilerin teknofest basarisi 2 Ph4ThW2U OMÜ’lü öğrencilerin TEKNOFEST başarısı

Ondokuz Mayıs Üniversitesi (OMÜ) Ziraat Fakültesi Tarımsal Biyoteknoloji Bölümü ile Elektrik-Elektronik Mühendisliği öğrencilerinin geliştirmiş oldukları projeler TEKNOFEST’ten ödüllerle döndü.
OMÜ Ziraat Fakültesi Tarımsal Biyoteknoloji Bölümü öğrencileri “Milli Tohum Hamlesi” sloganı ile yola çıktı. ‘Genom Avcıları’ ismi ile yarışmaya katılan takım yapmış oldukları proje ile Biyoteknoloji İnovasyon kategorisinde Türkiye birincisi oldu. Türkiye tarımında yaygın olarak kullanılan hibrit tohumun üretim maliyetinin yüksek ve üretimin sınırlı olduğunu belirten Genom Avcıları Takımı, bu probleme çözüm bulmak amacıyla “CRISPR-Cas9 Genom Düzenleme Aracılığı ile Erkek Kısır Domates Bitkilerinin Geliştirilmesi” projesini hayata geçirdi. Doç. Dr. Musa Kavasın danışmanlığını yaptığı ve doktora öğrencileri Zafer Seçgin ile Gökhan Gökdemir’in yer aldığı proje kazandığı birincilikle Üniversiteyi gururlandırdı.
Türkiye’de kullanılan tohumlar hibrit tohum olması ve maliyet acısından yüksek olduğu için bu projeyi yaptıklarını belirten Zafer Seçgin, “Projemizde ‘CRISPR-Cas9’ yöntemini kullanarak hibrit tohum üretiminde maliyeti düşürmeyi hedefledik. Hibrit tohum üretiminde işgücü gerektiren durumlar oluyor. İşgücü ve bu işlemin bazı zorlukları önlemek amacıyla polen oluşumunda sorumlu bazı genleri susturduk. Erkek genleri susturmamız sonucunda hibrit tohum üretimindeki en büyük maliyetin önüne geçmiş olduk. Bizim sistemimiz dünyadaki birçok sistemden farklı yönü doğrudan domates bitkisine enjeksiyon yöntemi ile uygulamak oldu” dedi.
“İlk defa biz uyguladık”
Genom Avcıları ile ilgili bilgi veren Doç. Dr. Musa Kavas, “Nisan ayında ‘Genom Avcıları’ takımını kurma kararı aldık. Domateste genom işlenmesine yönelik bir proje hazırlandı. Bu kapsamda seçtiğimiz gen, polen oluşumunun engellenmesine yönelik bir gen. Literatürde yaygın olarak kullanılan ‘CRISPR’ yöntemini kullanarak bu genin susturulmasını hedefledik. İlk defa biz bir bitkiye bu yöntemi uygulayarak polensiz bitkilerin oluşumunu sağladık” diye konuştu.
Atakuş İHA
TEKNOFEST’de gurur yaşatan bir diğer proje ise Mühendislik Fakültesi Elektrik-Elektronik Mühendisliği öğrencilerinden oluşan Atakuş İHA Takımı’ndan geldi. ‘Döner Kanat İHA’ kategorisinde Yerli yazılım ödülünü alan Atakuş İHA Takımı’nda Deniz Can Aykurt takım kaptanı, Hazal Kara takım pilotu, Hüseyin Can Küçüksezer, Mehmet Kaan Yılmaz ve Yusuf Dizdar ise takım üyesi olarak yarışmada yer aldı.
“Çıtayı çok yükseğe koyduk”
Projeleri ile diğer öğrencilere örnek olduğunu belirten Dr. Öğr. Üyesi İdris Sancaktar, “Şubat ayında başlattığımız bir çalışma. Drone’nun gövdesini oluşturduk son yazılımlara başladık. Yazılım 2 ay kadar bir süreç aldı. Arkadaşlarımızın bu sene okulu bitirmiyor olması gelecek öğrencilere de bu işi taşımak için büyük bir avantaj. Böylece kendi edindikleri deneyimleri, tecrübeleri kendilerinden sonraki öğrencilere de aktarmış olacaklar. Çırağın yetişmesi bakımından önemli bir şey birbirlerinin deneyimlerini aktarmaları bazen hocaların söylediklerinden daha önemli oluyor. Fakat çıtayı çok yükseğe koyduk seneye en az böyle bir ödülü almamız gerekecek. Bu bizim ve öğrencilerimizin daha çok çalışması gerektiği anlamına geliyor. İnşallah bundan sonraki senelerde de Üniversitemize, öğrencilerimize faydalı bir şey yapmış oluruz” şeklinde konuştu.
Drone yapım aşamalarından bahseden takım kaptanı Deniz Can Aykurt, “Araştırmalarımızı tamamladıktan sonra temel uçuş gereksinimleri havalanış, yükseliş ve otonom olarak yani kendi kendine yolunu bulabilmesi. Ona atanan görevleri otonom olarak yapmasını sağlayacak yazılımı geliştirdik. Son 2 ayda yoğun bir yazılım çalışması yürüttük. Kendi yazdığımız devre kartını 1 hafta 10 günlük bir süreçte üretip testlerine başladık. Yarışma bizim için çok güzel bir tecrübe oldu. Orada 101 takım bulunuyordu. Bu takımlar içerisinde farkımızı koyduğumuz için kendi ürettiğimiz yazılımın başarılı olması bizi mutlu etti” ifadelerini kullandı.